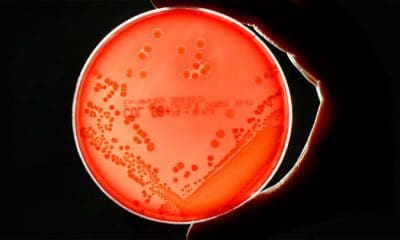
Fabrizio Bensch / Reuters
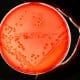
Fabrizio Bensch / Reuters

Algunas personas que van al gimnasio varias veces a la semana no alcanzan su peso ideal. ¿A qué se debe?



Científicos han usado los datos de 110.000 islandeses para determinar la relación entre la capacidad mental y las perspectivas de reproducción.

Una infección que acabó con la vida de una mujer en EE.UU. no pudo tratarse con ninguna medicación, lo hace sospechar que una bacteria sin el...



El zoólogo y ecologista holandés Ronald Goderich ha anunciado que está a punto de recuperar la antigua raza de vacas salvajes, ‘recreada’ por los nazis y...



Investigadores de la Universidad Nacional de Investigación Tecnológica ‘MiSiS’ de Moscú han desarrollado un metamaterial capaz de conferir capacidades furtivas a vehículos blindados y carros de...



Aunque pueda parecer la trama de una película de ciencia ficción, existe una forma de conocer cuál será su salud futura.



Las técnicas existentes para determinar el momento de la muerte son conocidas por su escasa fiabilidad, destacan los investigadores.



Las técnicas existentes para determinar el momento de la muerte son conocidas por su escasa fiabilidad, destacan los investigadores.



La enorme fuerza gravitatoria de la estrella Gliese 710 a su paso por el Sistema Solar podría desencadenar una lluvia de cometas en dirección a la...



La enorme fuerza gravitatoria de la estrella Gliese 710 a su paso por el Sistema Solar podría desencadenar una lluvia de cometas en dirección a la...